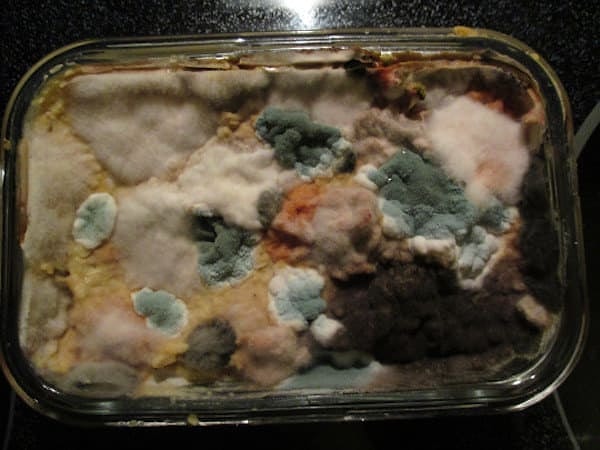
18. И снова пушистики

Если вы не сможете досмотреть эти фото до конца, то у вас сеплофобия!
Сеплофобия - страх гниющей материи. Если вас передергивает при виде заплесневелой еды, то следующие фотографии вам точно 'понравятся'!
Читайте продолжение новости внизу

Реклама
1. Так выглядит гниющая картошка...

Читайте продолжение новости внизу

Реклама
2. Рвотный рефлекс уже зарождается во мне...

3. А как вам эта пушистая клубника?

4. Мммм, аппетитненько!

5. Этот йогурт так и не дождался своей участи..

Читайте продолжение новости внизу

Реклама
6. 😖😖😖

7. Съели бы этот бывший лимон за 1000 долларов?

8. Знакомая картина?

9. 😖😖

10. Вы все еще тут?

Читайте продолжение новости внизу

Реклама
11. Похоже на морское дно....

12. Блинчики в плесневелом соусе 😔😔

13. Отврат 😓

14. Был арбуз, да сплыл!

15. Этот кофе похож на Землю, снятую со спутника... ☕

Читайте продолжение новости внизу

Реклама
16. 😑😐

17. Буээээ

18. И снова пушистики
19. А это был лук

20. 🍕😭

Читайте продолжение новости внизу

Реклама
21. Плесень поглощает все вокруг 😣😣

22. Ох, ох, ох

23. 😷😷😷

24. Если вы все еще здесь, вот вам немного утренней кашки

25. А тут еще и червячки подоспели..

🤔
Читайте продолжение новости внизу

Реклама
26. А этот рельеф похож на горы из окна самолета...

27. Нямка!

Загляните в холодильник! Мы почти на 100% уверены, что там вы найдете кое-что из увиденного!
Эмодзи и комментарии внизу

Реклама
Keşfet ile ziyaret ettiğin tüm kategorileri tek akışta gör!


Напишите комментарий